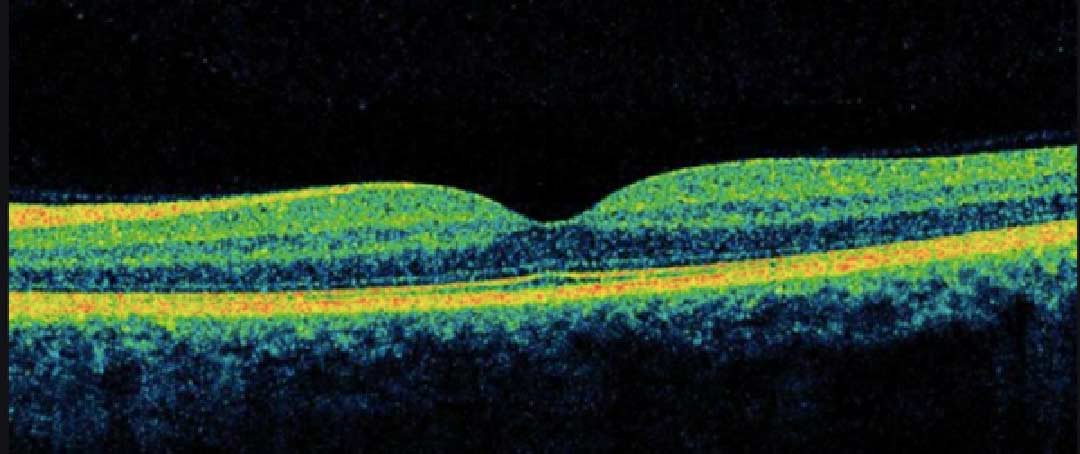

One of the eye disease that is becoming common among elderly in Malaysia is Macuar Hole. Read more about it in this article. You may find one or two things you have not had knowledge about but important for you to know especially if you have elderly parents.
FACT 1 : What Is Macular Hole?
In a normal condition, our eyes is similar to how your old camera functions. There’s lense in front eye and a layer of film at the back. The optic nerve called retina resembles a film in a camera.
The centre of eyesight located on the retina called macular
This part is used to see objects positioned right inside our straight vision in front of us
Macular hole is a disease that is caused by a hole at the centre of the eye.
Refer below picture to understand more :

FACT 2 : What Causes Macular Hole?
The vast majority of cases have no obvious cause.
Commonly affect those aged 60 to 80
Sometimes it can happen in younger patients if it is associated with other eye problem such as retinal tear or any inflammation,
One possible risk factor is a condition called vitreomacular traction. As you get older, the vitreous jelly in the middle of your eye starts to pull away from the retina and macula at the back of the eye. If some of the vitreous jelly remains attached, it can lead to a macular hole.
FACT 3 : What Are The Symptoms?
In the early stages, a macular hole can
cause blurred and distorted vision.
Straight lines may look wavy or bowed, and
you may have trouble reading small print.
After a while, you may see a small black patch or a “missing patch” in the centre of your vision.
You won’t feel any pain and the condition doesn’t lead to a total loss of sight.

FACT 4 : How Do We Treat Macular Hole?
A macular hole can often be repaired using an operation called a vitrectomy.
No eye drop or laser treatment can cure a macular hole.
The operation is successful in closing the hole in around 9 out of 10 people who’ve had the hole for less than 6 months.
If the hole has been present for a year or longer, the success rate will be lower.
Even if surgery does not close the hole, your vision will usually at least become stable, and you may find you have less vision distortion.
In a minority of patients, the hole does not close despite surgery, and the central vision can continue to deteriorate. However, a second operation can still be successful in closing the hole.

FACT 5 : What Do We Do During Surgery?
First, the vitreous jelly is removed (vitrectomy) and then a very delicate layer (the inner limiting membrane) is carefully peeled off the surface of the retina around the hole to release the forces that keep the hole open.
The eye is then filled with a temporary gas bubble, which presses the hole flat onto the back of the eye to help it seal.
The bubble of gas will block the vision while it’s present, but it slowly disappears over a period of about 6 to 8 weeks, depending on the type of gas used.
Macular hole surgery usually lasts about an hour and can be done while you’re awake (under local anaesthetic) or asleep (under general anaesthetic).
Most patients opt for a local anaesthetic, which involves a numbing injection around the eye, so no pain is felt during the operation.
FACT 6 : What To Expect After The Surgery During The Recovery Period?
Temporary Poor Vision
With the gas in place, the vision in your eye will be very poor – a bit like having your eye open under water.
Your balance may be affected and you’ll have trouble judging distances, so be aware of steps and kerbs. You may have problems with activities such as pouring liquids or picking up objects.
It generally takes 6 to 8 weeks for the gas to be absorbed and vision to improve.
FACT 7 : What To Do After The Operation?
Once at home, you may have to spend several hours during the day with your head held still and in a specific position, called posturing.
The aim of lying or sitting face down is to keep the gas bubble in contact with the hole as much as possible, to encourage it to close.
f you’re asked to do some face-down posturing, your head should be positioned so the tip of your nose points straight down to the ground. This could be done sitting at a table, or lying flat on your stomach on a bed or sofa. Your doctor will advise you on whether you need to do this and, if so, for how long.
You may be advised to avoid sleeping on your back following surgery, to make sure the gas bubble is in contact with the macular hole as much as possible.
You must not fly or travel to high altitude on land while the gas bubble is still in your eye (up to 12 weeks after surgery).
If you ignore this, the bubble may expand at altitude, causing very high pressure inside your eye. This will result in severe pain and permanent loss of vision.
You probably won’t be able to drive for 6 to 8 weeks after your operation while the gas bubble is still present in your eye.
Contact your ophthalmologist immediately or go to your nearest eye A&E department if at any time:
- you’re in severe pain
- your vision gets worse than it was on the day after the surgery
- You’ll usually be prescribed 2 or 3 types of eye drops to take after surgery:
FACT 8 : What NOT TO DO?
For the first few weeks after you return home, you may need to avoid:
- rubbing your eye – you may be asked to wear an eyepatch
- swimming – to avoid infection from the water
- strenuous exercise
- wearing eye make-up

FACT 9 : What Is The Complication From The Operation?
You’ll almost certainly get a cataract after the surgery, usually within a year if you’ve not already had a cataract operation. This means the natural lens in your eye has gone cloudy. If you do already have a cataract, it may be removed at the same time the hole is being repaired.
Retinal detachment is when the retina detaches from the back of the eye. It happens in around 6%of people having macular hole surgery. This can potentially cause blindness, but it’s usually repairable in a further operation.
Bleeding occurs very rarely, but severe bleeding within the eye can result in blindness.
Summary
Eventhough the frequency of patient reported in Malaysia with this disease is still considered low, but it is important for us to get educated of this disease especially for the elderly and those who involve in a high risk environment.
Share this article to your loved ones so that you get educated about macular hole. Hopefully this article benefits you and answering the burning question about macular hole.
